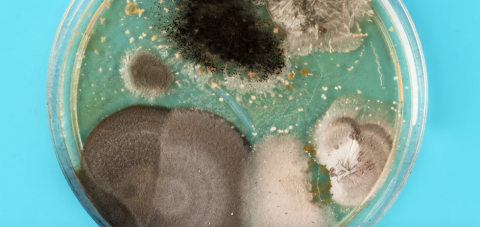

Intentamos presentarte publicidad respectuosa con el lector, que además ayuda a mantener este medio de comunicación y ofrecerte información de calidad.
Por eso te pedimos que nos apoyes y desactives el bloqueador de anuncios. Gracias.
Continuar...
Todas las noticias de
MASPALOMAS AHORASanidad notifica 79 casos de COVID 19 y dos fallecimientos este sábado
MASPALOMAS AHORA | EFE
La Consejería de Sanidad del Gobierno de Canarias ha notificado hoy 79 nuevos casos de covid 19 y el fallecimiento de dos mujeres de 95 y 85 años con patologías previas y que se encontraban ingresadas en un hospital.
La Incidencia Acumulada a los 7 días en Canarias se sitúa en 31,48 casos por cada 100.000 habitantes y a los 14 días en los 68,2 casos por 100.000 habitantes.
Por islas, Tenerife suma hoy 31 casos con un total de 45.086 casos acumulados y 1.218 casos activos epidemiológicamente y Gran Canaria cuenta con 35.996 casos acumulados, 27 más que el día anterior y 2.831 activos.
Lanzarote suma 15 nuevos casos con 6.738 acumulados y 88 activos epidemiológicamente; Fuerteventura tiene 4.314 casos acumulados con cuatro casos más que la jornada anterior y 321 activos.
La Palma registra un nuevo caso y cuenta con 1.091 acumulados y seis casos activos; El Hierro suma un [...] Leer más...
Prisión sin fianza para el autor del crimen de un italiano cuyo cuerpo apareció dentro de un coche en llamas en Pozo Izquierdo
MASPALOMAS AHORA | EFE
El Juzgado de Instrucción número 1 de San Bartolomé de Tirajana ha ordenado prisión preventiva incondicional sin fianza para el presunto autor material del crimen de un ciudadano italiano cuyo cuerpo apareció dentro de un coche en llamas en Pozo Izquierdo, en Gran Canaria.
El Tribunal Superior de Justicia de Canarias informa de que el titular del juzgado ha tomado durante el día de hoy declaración a ocho personas en relación con el crimen, a uno de ellos investigado como supuesto autor material del crimen, otros cinco como detenidos y otros dos como testigos que han acabado imputados.
El magistrado ha ordenado prisión preventiva incondicional sin fianza para el presunto autor material del crimen, calificado como asesinato, y para una mujer como supuesta cooperadora necesaria.
El supuesto autor material del crimen se ha negado a declarar.
Cuatro de los otros detenidos [...] Leer más...
176 personas en total en cuatro pateras durante el viernes
MASPALOMAS AHORA | EFE
1
Salvamento Marítimo ha rescatado a lo largo de este viernes a 176 inmigrantes que iban a bordo de cuatro pateras localizadas en aguas canarias, informaron e Efe fuentes de la sociedad estatal.
Los dos últimos rescates se han producido esta tarde: sendas embarcaciones neumáticas que navegaban cerca de Fuerteventura y Lanzarote y cuyos ocupantes, en ambos casos, contactaron con el 112 para solicitar ayuda.
En una de ellas, localizada a 7,5 kilómetros al sureste de Puerto del Rosario por una patrullera de la Guardia Civil, iban a bordo 55 personas de origen subsahariano: 40 hombres, 12 mujeres y tres niños. La Guardamar Concepción Arenal participó en el rescate.
En la otra, que se encuentra a unos 25 kilómetros de Lanzarote, viajan 35 personas.
Hacia allí se dirige la Salvamar Al Nair.
Por la mañana, Salvamento informó del rescate de 86 [...] Leer más...
¿Qué microorganismos compartimos al besarnos?
MASPALOMAS AHORA
Un beso puede ser fruto del cariño o la pasión pero ¿qué ofrecemos a la pareja que besamos? A veces, simplemente nos dejamos llevar pensando que solo compartimos amor, pero hay algo de lo que quizás no nos estemos percatando… ¡también intercambiamos muchos microorganismos!
Aunque no lo parezca, la boca es un complejo ecosistema donde pueden vivir hasta 700 especies de bacterias. Sus condiciones lo permiten: la saliva hace que sea un ambiente húmedo, tiene una temperatura moderada y un suministro constante de nutrientes. Por eso, es un sitio ideal para que crezcan bacterias.
Como la boca está llena de microorganismos, es evidente que podemos intercambiar muchos de ellos al besarnos. De hecho, según un estudio holandés realizado con estudiantes, en un beso apasionado de 10 segundos nos transferimos la friolera cantidad de 80 millones de bacterias.
¿Quién vive alrededor de nuestra lengua?
Leer más...
SuperFoxy, la heroína canina más famosa de Mogán, salta al teatro
MASPALOMAS AHORA
El Centro Cultural El Mocán ha sido testigo del estreno de “Las aventuras de SuperFoxy”, un musical ambientado en los cuentos de SuperFoxy, una perrita que cuando duerme tiene el poder de volar y hablar con otros animales y plantas, y además los usa para resolver cuanto problema le pueda surgir en su día a día por Mogán y otros rincones de la isla.
Este personaje está basado en Foxy, la mascota de su autora Natasha Betancor, una canadiense que llegó a Mogán hace 52 años. Foxy es muy querida por los vecinos y vecinas del casco del municipio, por donde pasea a diario desde que fuera rescatada por Betancor hace ya 15 años después tras ser abandonada en un campo de golf. Además esta perrita es una superheroína dentro y fuera de la ficción, ya que a pesar de padecer epilepsia ha logrado mantener la enfermedad a raya gracias a tratamientos naturales.
Ya hace un año que el primer cuento de SuperFoxy llegó a manos de los jóvenes [...] Leer más...
La feht agradece a Sanidad la amplicación del horario nocturno
MASPALOMAS AHORA
La Asociación de Bares, Cafeterías, Restaurantes y Ocio Nocturno (integrada en la Federación de Empresarios de Hostelería y Turismo de Las Palmas-FEHT) y la propia Federación, muestran su satisfacción con el acuerdo alcanzado ayer en el seno del Consejo de Gobierno, de incrementar el horario de cierre de los establecimientos de ocio nocturno en los niveles de alerta 1, 2 y 3, al tiempo que felicitan de forma personal al Consejero de Sanidad, Blas Trujillo y al Director del Servicio Canario de Salud, Conrado Domíguez, por el trabajo desarrollado durante todos estos meses, que ha podido culminar con el antedicho acuerdo.
Con efectos inmediatos y vigencia hasta el próximo 31 de octubre, el ocio nocturno podrá mantener sus establecimientos abiertos, hasta las 4 de la mañana en los niveles de alerta 1 y 2; y hasta las 3 de la mañana en el nivel de alerta 3, tal y como aparece hoy viernes, publicado en el Boletín Oficial de Canarias, bajo la condición de [...] Leer más...
Día Internacional de los Microorganismos: sin ellos, usted no estaría leyendo este artículo
MASPALOMAS AHORA
Cada 17 de septiembre se celebra el Día Internacional de los Microorganismos. Dicha celebración parece contradictoria en medio de una pandemia, como si algo bueno pudiera salir de estos seres vivos. Los gérmenes nos causan enfermedades e incluso la muerte, pero no permitamos que el árbol no nos deje ver el bosque: la inmensa mayoría de los microorganismos son buena gente. Es más, son necesarios para nuestra supervivencia y la todos los ecosistemas del planeta, así que se merecen que celebremos su día.
Una de las 190 cartas que el holandés Anton Van Leeuwenhoek escribió a la Royal Society entre los años 1673 y 1723. Wikimedia Commons / WikiProject Royal Society / Mike Peel
Pero, ¿por qué el 17 de septiembre?
Probablemente el 17 de septiembre de 1683 amaneció frío y lluvioso en la pequeña ciudad holandesa de Delft, famosa por sus canales. Anton van Leeuwenhoek, comerciante de telas [...] Leer más...
Llegan 86 inmigrantes, once mujeres y diez niños, en dos pateras localizadas a 50 y 85 kilómetros del sur de Gran Canaria
MASPALOMAS AHORA | EFE
Salvamento Marítimo ha rescatado este viernes a 86 inmigrantes, entre ellos once mujeres y diez niños, en dos pateras localizadas a 50 y 85 kilómetros de distancia del sur de Gran Canaria, respectivamente.
Según ha informado esta sociedad estatal, las dos embarcaciones fueron avistadas por el avión de reconocimiento Sasemar 103, que facilitó su posición a la Salvamar Macondo.
La primera patera lleva a bordo a 36 inmigrantes magrebíes (35 varones y una mujer) y la segunda a otros 52 de origen subsahariano (32 varones, diez mujeres y diez niños).
La Salvamar Macondo navega con ellos de regreso al puerto de Arguineguín, adonde está previsto que llegue sobre las 15.30 horas (hora canaria). Leer más...
123 casos de COVID-19 y cuatro personas fallecidas en las últimas 24 horas
MASPALOMAS AHORA
La Consejería de Sanidad del Gobierno de Canarias notifica hoy 123 nuevos casos de coronavirus COVID-19. El total de casos acumulados en Canarias es de 94.002 con 4.719 activos, de los cuales 49 están ingresados en UCI y 244 permanecen hospitalizados. Hasta hoy se ha realizado un total de 2.076.287 pruebas diagnósticas en las Islas, de las que 4.494 se corresponden al día de ayer.
En las últimas horas se ha producido el fallecimiento de cuatro personas: dos mujeres y un varón en Tenerife, de 96, 71 y 72 años, y una mujer Gran Canaria de 76 años. Todos los fallecidos padecían patologías previas y estaban ingresados en el hospital.
La Incidencia Acumulada a los 7 días en Canarias se sitúa en 33,55 casos por cada 100.000 habitantes y a los 14 días en los 71,05 casos por 100.000 habitantes.
Por islas, Tenerife suma hoy 45 casos con un total de 45.055 casos acumulados y 1.416 casos activos [...] Leer más...
Antonio Olivera aclara que Canarias debe estar preparada para la llegada de inmigrantes irregulares en pateras dadas las condiciones favorables del mar
MASPALOMAS AHORA | EFE
Canarias debe estar preparada para la llegada de inmigrantes irregulares en más pateras o cayucos dadas las condiciones favorables del mar para la navegación en este periodo, ha manifestado el viceconsejero de Presidencia, Antonio Olivera.
En la rueda de prensa que ha ofrecido tras la reunión del Consejo de Gobierno, Olivera ha destacado que existen recursos para los inmigrantes adultos que llegan a las islas y se "está actuando de forma ágil" para evitar episodios como los vividos el pasado año en estas fechas.
En cuanto a los menores extranjeros no acompañados, el viceconsejero ha señalado que se ha iniciado un proceso negociador con Estado con para encontrar mecanismos con el fin de compartir de forma solidaria la responsabilidad que supone para el Gobierno de Canarias su atención y garantizar adaptación.
Olivera ha insistido en que el reparto solidario entre regiones sería lo recomendable y [...] Leer más...